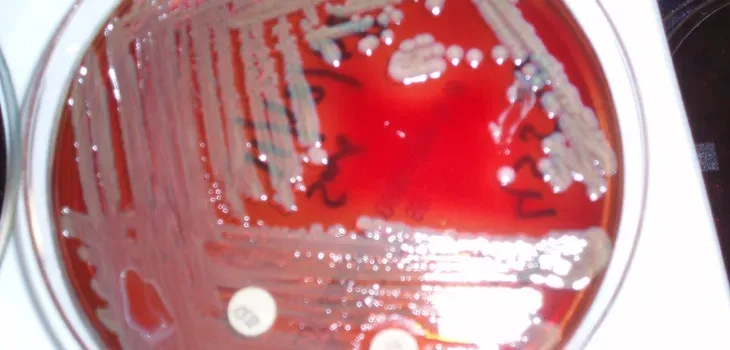
Osteomyelitis as a result of Kingella kingae

Is your toddler suddenly limping or refusing to walk? A Kingella kingae infection could be the hidden culprit behind their bone or joint pain. Understanding this common bacterium is the first crucial step toward a swift diagnosis and effective treatment for your child.
What are the main causes of Kingella kingae Infection?
- Kingella kingae is a bacterium commonly found in the respiratory tracts, specifically the throat and nose, of many healthy young children.
- The infection typically occurs when these bacteria manage to enter the bloodstream, often following a mild viral upper respiratory tract infection.
- Minor breaks in the lining of the throat, caused by viruses or even teething, can allow the bacteria to invade and spread elsewhere.

Key symptoms of Kingella kingae Infection to watch for
- Observe for a sudden onset of limping or a refusal to bear weight on a leg, a primary sign of septic arthritis in toddlers.
- The child may present with only a low-grade fever, increased irritability, and localized pain over a bone, indicating potential osteomyelitis.
- In rare but serious cases, the infection can lead to endocarditis, involving more severe symptoms like high fever, fatigue, and breathing difficulties.
How can you prevent Kingella kingae Infection effectively?
- Maintaining excellent general hygiene, including frequent and thorough handwashing for children and caregivers, helps limit the spread of associated viruses.
- Promptly addressing respiratory illnesses and oral sores may help prevent the bacteria from gaining entry into the bloodstream and causing a systemic infection.
- Ensuring your child is current on all routine immunizations is crucial for maintaining a robust immune system that can fight off infections.
>>> Discover more: Human bocavirus - A common cause of respiratory illness in kids
Image of the disease Kingella kingae Infection

>>> See more: Human papillomavirus (HPV) infection - A guide to symptoms, vaccines, and cancer risk
Early diagnosis is vital for a full recovery from a Kingella kingae infection. If your child shows these symptoms, don't delay. Consult a paediatric specialist to ensure they receive an accurate diagnosis and the proper treatment for their condition.
>>> Details at: Impetigo - How to treat this contagious skin infection






